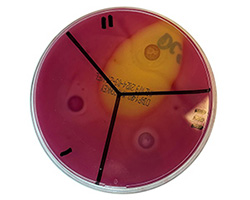

The Time is Now for Molecular Iodine
Molecular iodine, I2, is the only microbiocidal iodine species. I2 does not contribute to cytotoxicity.
Traditional iodine’s use is limited due to toxicity, staining, and irritation.
I2Pure has not only eclipsed traditional iodine issues but has unleashed molecular iodine’s full biocidal power.
Zero Resistance
No pathogen has ever demonstrated resistance to iodine. I2Pure makes iodine a keystone ingredient in multiple forms for a variety of products and indications.
Bio Nutrient
The healthy human thyroid uses molecular iodine in a steady state up to 800 ppm. The thyroid converts the iodide we consume into sodium-iodide symporter where it is oxidized into molecular iodine and stored in the follicular lumen.
Strong Safety Profile
I2Pure contracted an independent lab to test 15,000 ppm of molecular iodine on human skin for 24 hours. The result: the 15,000-ppm molecular iodine formulation had the same cytotoxicity profile as saline.

Patented Iodine Technology
The list of potential applications that can be improved by iodine is virtually endless. From healthcare and veterinary care to water disinfection and industrial cleaning applications, iodine holds the promise of reducing or even eliminating bioburdens. I2Pure technology can be applied to a wide-range of medical and implanted devices, solutions, bio polymers and coatings.
I2Pure's technology demonstrates impressive zones of inhibition - the area where bacteria, viruses and fungi are neutralized using I2Pure technology.

Molecular iodine and skin
Patented, non-toxic molecular iodine platform.
- Manufactured complexed formula.
- Highly acidic.
- Contains multiple species of iodine.
- Toxic, irritating, and staining.
- Limited persistency.
- 1-5 PPM molecular iodine (I2) - the ONLY active biocide in the formula.
- Formula serves solely as a carrier of I2.
There isn't just one form of iodine.
There are nine different species of iodine.
- Naturally-occurring bio-nutrient produced by all vertebrates on earth.
- Non-toxic.
- Non-staining.
- High persistence on and in tissues.
- Can be integrated with a variety of products at significantly higher PPM, increasing biocidal / antimicrobial power.